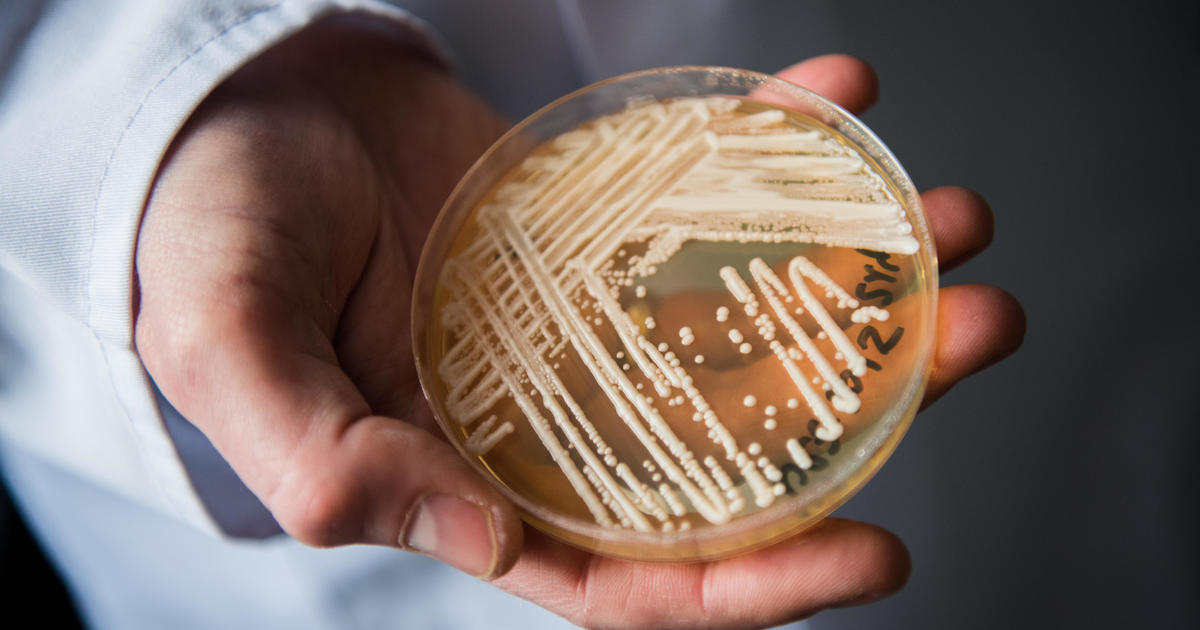

Key takeaways:
- The number of people diagnosed with infections and those carrying the fungus has been rising at an alarming rate since it was first reported in the U.S. in 2016.
- The CDC is urging health care facilities to take steps to prevent the spread of C. auris, including proper hand hygiene, wearing protective equipment, and cleaning and disinfecting surfaces.
- The CDC is also working to develop new treatments and diagnostic tests for the fungus, and is urging health care providers to be aware of the potential for C. auris infection.
The Centers for Disease Control and Prevention (CDC) has issued a warning about the rapid spread of a drug-resistant fungus, Candida auris, in U.S. health care facilities. According to a new government study, the number of people diagnosed with infections and those carrying the fungus has been rising at an alarming rate since it was first reported in the U.S. in 2016.
The fungus, a type of yeast, can cause severe illness in people with weakened immune systems. In 2020, 756 cases of C. auris were reported to the CDC. In 2021, that number had increased to 1,471, a 95% increase.
Dr. Meghan Lyman, chief medical officer in the CDC’s Mycotic Diseases Branch and lead author of the study, said in an interview: “The increases, especially in the most recent years, are really concerning to us.”
The CDC is urging health care facilities to take steps to prevent the spread of C. auris. This includes proper hand hygiene, wearing protective equipment, and cleaning and disinfecting surfaces. The CDC is also working to develop new treatments and diagnostic tests for the fungus.
The CDC is urging health care providers to be aware of the potential for C. auris infection and to take steps to prevent its spread. If left unchecked, the fungus could become a major public health threat.

Be First to Comment